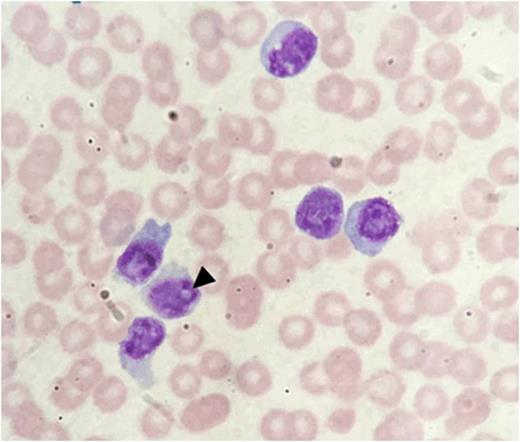
Figure 1.

Small-cell variant of T-cell prolymphocyticleukaemia (T-PLL) is a rare entity, with only 32 cases described1.
A 64 year old asymptomatic female presented with lymphocytosis (15.6 x 10^9/L), already present 9 years earlier.
Clinical examination was normal. Flow cytometry demonstrated 94% of lymphocytes were CD3+/CD4+/CD8- T cells with normal expression of CD2/5/7. V-beta T cell receptor repertoire and T cell gene rearrangement confirmedmonoclonality. Peripheral blood morphology showed small mature lymphocytes without cytoplasmic granulation and only a rare form showing indistinct nucleoli [arrowhead, figure 1].
Lymphocyte count initially increased slowly (to 23.7 x 10^9/L 10 months after diagnosis), then rapidly (47.2 x 10^9/L, 90.8 x 10^9/L, 151.6 x 10^9/L, 201.6 x 10^9/L at 16 months, 22 months, 28 months and 29 months after diagnosis respectively). By 29 months thrombocytopenia (platelet count 24 x 10^9/L), elevated LDH and spontaneous bruising developed. CT scan did not showadenopathyor splenomegaly. Bone marrow biopsy showed extensive infiltration by small, mature lymphocytes with an identicalimmunophenotypeto that seen at diagnosis.
Treatment with CHEOP for 2 cycles did not achieve any response and causedmyelosupression, GI upset and fatigue. Progressive disease was seen during 2 cycles ofpanobinostatwith development ofadenopathy, splenomegaly and rising lymphocyte count.Alemtuzumabproduced rapid disease response with normalisation of lymphocyte count and resolution of theadenopathyand splenomegaly.Bone marrow biopsy after 28 doses ofalemtuzumabshowed no morphological orimmunophenotypicevidence of residual lymphoma.The patient declined to undertake consolidative autologous peripheral blood stem cell transplant at best response. Unfortunately the patient relapsed 4 months later with progressive lymphocytosis, splenomegaly and high LDH. Gemcitabine was given without response and the patient passed away 45 months after diagnosis.
Comprehensive genetic analysis was undertaken using G-banded karyotyping, M-FISH, allele-specific FISH for TCL1A and SNP array. Multiple complex rearrangements were detected with abnormalities involving chromosomes 2, 3, 7, 8, 9, 10, 11, 12, 13, 14, 17, 18, 20 and 22, but lacking the inv(14)(q11.2q32) commonly seen in typical T-PLL. In total, 58 copy number changes were identified, but the sole region of copy number gain was a 21Mb duplication of chromosome 14 distal to band 14q31.3. It was present in approximately 90% cells, consistent with the presence of a der(21)t(14;21)(q31;p11.2) observed by metaphase cytogeneticsand resulting in trisomy of the TCL1A locus seen on allele-specific FISH for TCL1A [arrowheads, figure 2]. Some changes detected by SNP array were present in virtually all cells and were thus likely to be have occurred early during tumour evolution. Other subclonalchanges were seen in approximately 90%, 75% or 60% cells respectively, indicating the presence of four distinct cell lines in total. Deletion of the distal portion of 12p was present in virtually all cells, in keeping with the presence of either the dicentric12;13or the dicentric12;14 chromosome in all malignant cells. Of note, a cytogenetically cryptic 1.5Mb deletion at 2p23.2 resulting in deletion of DNMT3A was also an early event, as was a heterozygous deletion of DNMT3B at 20q11.2. The deletion of DNMT3B was seen in association withchromothripsis-like changes on chromosome 20. Despite demonstrated rearrangement of both copies of chromosome 20 by metaphasecytogenetics, no regions of homozygous deletion on chromosome 20 were identified.
Typically cases of T-PLL, small cell variant, possess rearrangements of 14q11, often theparacentricinversion typically seen in standard T-PLL, but with other translocations involving the 14q11 locus also described. Thet(14;21) seen in this case demonstrates a novel mechanism of TCL1A dysregulation, not previously described in T-PLL.
1Rashidi, A. and Fisher, S. I. (2015), T-cell chronic lymphocyticleukemia or small-cell variant of T-cellprolymphocyticleukemia: a historical perspective and search for consensus.Eur JHaematol, 95: 199-210.doi:10.1111/ejh.12560
No relevant conflicts of interest to declare.
Author notes
Asterisk with author names denotes non-ASH members.

This feature is available to Subscribers Only
Sign In or Create an Account Close Modal